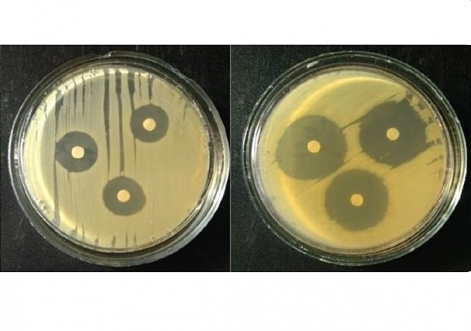
Композиты наночастиц серебра с антибиотиком могут стать антимикробными препаратами нового поколения

Композиты наночастиц серебра с антибиотиком могут стать антимикробными препаратами нового поколения
25 августа 2022 г. Институт химии и химической технологии СО РАН
Красноярские ученые синтезировали композиты из наночастиц серебра и антибиотиков. Полученные компоненты обладают высокой антибактериальной активностью, превышающей обычные антибиотики. Результаты исследования опубликованы в журнале Inorganic Chemistry Communications.
Медики все чаще отмечают, что у патогенных бактерий вырабатывается устойчивость к различным антибиотикам. Число видов таких бактерий постоянно растет, а поиск и разработка новых и действенных антибиотиков идет медленно. В результате бактериальная антибиотикорезистентность стала угрозой для здравоохранения.
Ученые ФИЦ «Красноярский научный центр СО РАН», СФУ и СибГУ им. М.Ф. Решетнёва синтезировали антибактериальные композиты на основе наночастиц серебра покрытых антибиотиками. Из-за ингибирующих свойств обоих компонентов новый материал успешно расправляется с патогенными бактериями и в перспективе может быть использован в борьбе с бактериальными заболеваниями.
Наноматериалы обладают уникальными свойствами. Например, наночастицы серебра отличаются антибактериальными, антиоксидантными, противовоспалительными, антитромбоцитарными и противоопухолевыми свойствами; поэтому они активно используются в медицине. Исследователи добавляли к наночастицам серебра антибиотики цефалоспоринового ряда (динатрий цефтриаксон, цефотаксим натрия, цефазолин натрия и цефоперазон натрия). Такие антибиотики часто используются против бактериальных заболеваний, однако резистентность бактерий к ним возрастает. Исследователи установили, что создание композита, соединяющего антибиотики с наночастицами серебра, может уменьшить эту проблему.
Антибактериальную активность полученных композитов ученые проверяли на золотистом стафилококке и кишечной палочке. Все композиты из наночастиц серебра с антибиотиком проявляли более высокую, чем у чистых антибиотиков, антибактериальную активность.
 «Разработка антибактериальных препаратов с новой химической структурой сложна, дорогостояща и требует много времени. В то же время разработка новых комбинированных препаратов на основе известных антибиотиков может оказаться более эффективной, менее дорогостоящей и трудоемкой. Мы синтезировали композит наночастиц серебра в сочетании с различными цефалоспориновыми антибиотиками. Затем мы изучили их ингибирующие возможности в отношении золотистого стафилококка и кишечной палочки. Синтезированные композитные материалы продемонстрировали значительную антибактериальную активность. Антибиотики цефалоспорины проявляют бактерицидное действие, подавляя активность бактериальных ферментов, препятствуя синтезу пептидогликанового слоя на стадии размножения и, тем самым, повреждая клеточную стенку бактерий. Наночастицы серебра, со своей стороны, оказывают губительное действие на мембрану, метаболизм и генетический аппарат бактерий. Таким образом, оба компонента комплекса оказывают повреждающее действие на клеточную стенку исследованных бактерий», — рассказал Сергей Воробьев кандидат химических наук, научный сотрудник Института химии и химической технологии СО РАН.
«Разработка антибактериальных препаратов с новой химической структурой сложна, дорогостояща и требует много времени. В то же время разработка новых комбинированных препаратов на основе известных антибиотиков может оказаться более эффективной, менее дорогостоящей и трудоемкой. Мы синтезировали композит наночастиц серебра в сочетании с различными цефалоспориновыми антибиотиками. Затем мы изучили их ингибирующие возможности в отношении золотистого стафилококка и кишечной палочки. Синтезированные композитные материалы продемонстрировали значительную антибактериальную активность. Антибиотики цефалоспорины проявляют бактерицидное действие, подавляя активность бактериальных ферментов, препятствуя синтезу пептидогликанового слоя на стадии размножения и, тем самым, повреждая клеточную стенку бактерий. Наночастицы серебра, со своей стороны, оказывают губительное действие на мембрану, метаболизм и генетический аппарат бактерий. Таким образом, оба компонента комплекса оказывают повреждающее действие на клеточную стенку исследованных бактерий», — рассказал Сергей Воробьев кандидат химических наук, научный сотрудник Института химии и химической технологии СО РАН.
Работа выполнена при поддержке Российского научного фонда (проект № 18-73-00142).
Поделиться:
